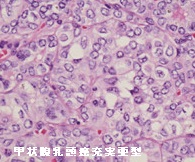
甲状腺乳頭癌充実亜型 組織診 甲状腺乳頭癌充実亜型 組織診

甲状腺びまん性硬化型乳頭癌(DSPTC) ・(小児)甲状腺乳頭癌充実亜型[橋本病 バセドウ病 甲状腺エコー検査 長崎甲状腺クリニック 大阪]
甲状腺:専門の検査/治療/知見① 橋本病 バセドウ病 甲状腺エコー 長崎甲状腺クリニック大阪
甲状腺専門の長崎甲状腺クリニック(大阪府大阪市東住吉区)院長が海外・国内論文に眼を通して得た知見、院長自身が大阪市立大学附属病院 代謝内分泌内科で得た知識・経験・行った研究、日本甲状腺学会で入手した知見です。
長崎甲状腺クリニック(大阪)以外の写真・図表はPubMed等において学術目的で使用可能なもの(Creative Commons License)、public health目的で官公庁・非営利団体等が公表したものを一部改変しています。引用元に感謝いたします。尚、本ページは長崎甲状腺クリニック(大阪)の経費で非営利的に運営されており、広告収入は一切得ておりません。
甲状腺・動脈硬化・内分泌代謝・糖尿病に御用の方は 甲状腺編 動脈硬化編 甲状腺以外のホルモンの病気(副甲状腺/副腎/下垂体/妊娠・不妊など) 糖尿病編 をクリックください
長崎甲状腺クリニック(大阪)は小児科ではありません。20歳未満の方の診療を行っておりません。
Summary
甲状腺びまん性硬化型乳頭癌(DSPTC)は若年女性に多く、RET/PTC 再配列が一般的。癌細胞はリンパ管内で増殖(癌性リンパ管症)し早期発見困難、進行早く早期に頚部リンパ節転移や肺転移、甲状腺エコーで、びまん性粒状石灰化、橋本病合併多く診断を困難に。穿刺細胞診でミラーボール状集塊・隔壁性細胞質内空胞・砂粒小体。チェルノブイリ原子力発電事故後に増加した甲状腺乳頭癌充実亜型は小児/若年者に多く、ヨード(ヨウ素)欠乏地域のため充実亜型構造に。ret/PTC3遺伝子変異が多く、成人では高増殖型。エコー所見は多彩、核は甲状腺乳頭癌の特徴的所見。
Keywords
小児,甲状腺,超音波,エコー,甲状腺びまん性硬化型乳頭癌,甲状腺癌,充実亜型,甲状腺乳頭癌,転移,細胞診
甲状腺びまん性硬化型乳頭癌(DSPTC)とは
小児甲状腺癌の約20%(甲状腺乳頭癌全体の0.3-5%)を占める甲状腺びまん性硬化型乳頭癌(diffuse sclerosing variant of papillary thyroid carcinoma:DSPTC)は、
- 若年女性に多い(31.2±12.4歳)(※66歳もある)
- BRAF変異、RAS変異は少なく、RET/PTC 再配列(RET/PTC1 rearrangement)が一般的(Histopathology. 2016 Jul;69(1):45-53.)
- 癌細胞はリンパ管内で増殖するため、早期発見は困難、見つかった段階で癌性リンパ管症
- 進行が早く、甲状腺内浸潤、両外側リンパ節転移の出現まで短期間
早期に頸部リンパ節転移(95.9%)(※診断時、ほぼ全例で頸部外側リンパ節転移)や肺転移(約5%)
対側中央区域リンパ節転移(50%)、対側リンパ節転移(66.7%)
- 橋本病(慢性甲状腺炎)の合併が多く(69.1%)、超音波(エコー)診断を困難にしている
- 甲状腺超音波(エコー)検査において、不均一な病変で
等エコー(48.4%)、びまん性粒状石灰化(52.3%)、血流は乏しい(71.6%)
[橋本病の甲状腺内に広範な、びまん性砂粒状・多発性粗大石灰化、乳癌の甲状腺転移と鑑別要]
[Clin Radiol. 2022 May;77(5):e356-e362.][Thyroid. 2009 Nov;19(11):1225-31.](※第62回 日本甲状腺学会 O5-3 甲状腺びまん性硬化型乳頭癌の発症経過の検討)
甲状腺びまん性硬化型乳頭癌(DSPTC)の診断
甲状腺びまん性硬化型乳頭癌(DSPTC)の診断は、
- 甲状腺エコーで、境界不明瞭で不均質な病変;等エコー(48.4%)、びまん性粒状石灰化(52.3%)、血流は乏しい(71.6%)[Clin Radiol. 2022 May;77(5):e356-e362.]
- 穿刺細胞診で、ミラーボール状集塊・隔壁性細胞質内空胞・砂粒小体
を認めれば確定します。
(エコー画像;Ultrasonography. 2017 Apr 36(2) 103–110.)
甲状腺びまん性硬化型乳頭癌の細胞診では、
- ミラーボール状集塊;リンパ球も含む
- ホブネイル細胞
- 隔壁性細胞質内空胞(液胞)
- 砂粒小体(石灰)
- 扁平上皮化生
- 橋本病のリンパ球を背景に認める
- 通常型乳頭癌に特徴的な核特徴がない
が特徴的です。
(The Bethesda System for Reporting Thyroid Cytopathology)[Cytopathology. 2014 Jun;25(3):199-204.]
病理学的には拡張したリンパ管内の腫瘍塞栓・リンパ管を介したびまん性病変・周囲間質組織の増生・高度なリンパ球浸潤,多数の砂粒体が特徴。
甲状腺びまん性硬化型乳頭癌(DSPTC)の鑑別診断
甲状腺びまん性硬化型乳頭癌(DSPTC)と鑑別診断すべきは、
甲状腺びまん性硬化型乳頭癌(DSPTC)の治療
甲状腺びまん性硬化型乳頭癌(DSPTC)の治療は、
- 甲状腺全摘出術と頚部リンパ節廓清[Cancer. 1990 Dec 1;66(11):2306-12.][World J Surg. 2020 Jan;44(1):155-162.]
- 肺転移に対してI-131 放射線治療(内照射)療を行うべきか。成人なら問題ないでしょうが、小児なら迷うところです。当然、その後の成長障害、2次発がんの危険は避けられません(2次発癌、second primary cancer)。答えはありませんが、肺転移巣は自然消滅する訳では無いので、やはり行った方が良いと思いますが・・。(第54回 日本甲状腺学会 P172 術後に低用量のアイソトープ治療を行っている5歳女児の甲状腺びまん性硬化型乳頭癌の1症例)
甲状腺びまん性硬化型乳頭癌(DSPTC)の予後
甲状腺びまん性硬化型乳頭癌(DSPTC)の予後は、
- 通常型甲状腺乳頭癌より予後不良との報告(Eur J Endocrinol. 2017 Apr;176(4):433-441.)
- 再発はほとんど無く予後悪くないとの報告
- 積極的治療で通常型乳頭癌と同じくらいの予後(再発率14%・癌関連死亡率3%)(Thyroid. 2016 Sep;26(9):1285-92.)
と様々で、意見が分かれています。
小児甲状腺乳頭癌充実亜型[充実型乳頭癌](Solid variant of papillary thyroid carcinoma:SVPTC)
小児甲状腺乳頭癌充実亜型[充実型乳頭癌](Solid variant of papillary thyroid carcinoma:SVPTC)は、(乳頭構造・濾胞構造を取らず)充実性に増殖する成分が全体の50%以上を占める甲状腺乳頭癌亜型です。核には甲状腺乳頭癌の特徴的所見を認めます。
チェルノブイリ(チョルノービリ)原子力発電事故後に増加し、放射線被曝が関連しますが、ヨード(ヨウ素)欠乏地域であったため乳頭構造・濾胞構造を取らず、充実構造になったと考えられます。
また、小児甲状腺乳頭癌充実亜型[充実型乳頭癌](SVPTC)は小児/若年者に多く、成人の通常型甲状腺乳頭癌にくらべret/PTC3遺伝子再配列が多い点が異なります(Cancer 104: 943-951, 2005)。
ヨード(ヨウ素)過剰地域の日本で、小児甲状腺乳頭癌充実亜型[充実型乳頭癌](SVPTC)はほとんどなく(乳頭癌全体の1-3%)、近いものでも濾胞構造が混在する充実濾胞型です。
伊藤病院がバセドウ病に合併した小児甲状腺乳頭癌充実亜型を報告しています。急激な増大と肺転移を認め、バセドウ病の甲状腺刺激抗体(TRAb,TSAb)が癌の増殖を刺激したと考えられます(バセドウ病に発生する甲状腺乳頭癌・甲状腺濾胞癌)。しかし、ヨード(ヨウ素)欠乏地域でないのに充実亜型になる理由は定かではありません。甲状腺刺激抗体(TRAb,TSAb)が乳頭癌細胞に増殖刺激を掛けた事が、関係あるのかもしれません。(第57回 日本甲状腺学会 P2-041 バセドウ病で通院中、4 年間で急速に発育した小児乳頭癌の一例)
小児甲状腺乳頭癌充実亜型・充実濾胞型ともに生命予後も極めてよいとされますが、通常型乳頭癌よりやや不良ともされます。
甲状腺乳頭癌充実亜型 超音波(エコー)所見
甲状腺乳頭癌充実亜型(SVPTC)の超音波(エコー)所見は多彩で、腺腫様結節に見えるものから、濾胞型乳頭癌の様なものまであります。そもそも、ヨード(ヨウ素)欠乏のため乳頭状構造にならなかっただけと考えれば、通常の甲状腺乳頭癌と差が無いのかもしれません。(写真;Cancer Cytopathol. 2015 Feb;123(2):71-81.)
甲状腺乳頭癌充実亜型の細胞診、組織診
成人の甲状腺乳頭癌充実亜型(Solid variant of papillary thyroid carcinoma:SVPTC)
野口病院の報告で甲状腺乳頭癌充実亜型(solid variant of papillary thyroid carcinoma:SVPTC)は、
- 全甲状腺乳頭癌手術症例の0.71%
- 年齢中央値は48歳(10 ~ 78 歳)、未成年例が15.8%
- 腫瘍長径中央値は1.9cm(1.0 ~5.7cm)
- 術前超音波検査で乳頭癌疑いが74%、濾胞癌疑いが11%
- 術前細胞診で悪性の判定が79%だったが、甲状腺乳頭癌充実亜型が示唆された症例は5%のみ
- 橋本病(慢性甲状腺炎)の合併が53%
だったそうです(第59回 日本甲状腺学会 P3-3-2 充実型乳頭癌(papillary carcinoma, solid variant)の検討。)
橋本病(慢性甲状腺炎)を伴うターナー症候群の22歳女性に発症した甲状腺乳頭癌充実亜型(SVPTC)の報告では、RET/PTC再構成、BRAF変異、RAS変異いずれも検出されなかったそうです。[Front Oncol. 2023 Nov 9;13:1150002.]
甲状腺乳頭癌充実亜型(SVPTC)の予後
甲状腺乳頭癌充実亜型(SVPTC)患者の予後に関する報告は少なく、異なる意見があります。
甲状腺乳頭癌充実亜型(SVPTC)患者は通常型乳頭癌患者と比較して転移の発生率がわずかに高い[Am J Surg Pathol. 2001 Dec;25(12):1478-84.]。
甲状腺乳頭癌充実亜型(SVPTC)患者は通常型甲状腺乳頭癌患者と比較して再発リスクが高い[Am J Surg Pathol. 2006 Nov;30(11):1420-6.]
甲状腺乳頭癌充実亜型は、高細胞型(tall cell variant )、円柱細胞型(columnar variant)、びょうくぎ型(hobnail variant)と同じく高増殖型で、通常型乳頭癌と比べ悪性度が高い(Adv Anat Pathol. 2018 May;25(3):172-179.)[Adv Ther. 2020 Jul;37(7):3112-3128.]。
甲状腺乳頭癌充実亜型は、通常型乳頭癌と比較して、血管浸潤、腫瘍再発、および癌死亡率のリスクが有意に高いと報告されています(Head Neck. 2018 Jul;40(7):1588-1597.)。
小児甲状腺濾胞癌は非常に珍しく、野口病院の報告によると小児甲状腺濾胞癌患者20例の特徴は、
- 平均年齢 17.3 歳(範囲11-20 歳)、男性2 例・女性18例
- 平均腫瘍径 27.9mm
- 転移リンパ節 1例、治療時の遠隔転移 0例
- 広範浸潤型 4例、微少浸潤型 16例(当然、被膜浸潤 20例全例)
- 血管浸襲 9例:原病死はいないものの、血管浸襲症例では再発し予後が不良
(第56回 日本甲状腺学会 YIA-7 小児甲状腺濾胞癌の臨床像)
小児甲状腺濾胞癌患者の53.3%はDICER1遺伝子変異を有します(その半数は元々DICER1症候群であることが分かっていた)。DICER1遺伝子変異以外には、PTEN過誤腫症候群[コーデン(Cowden)症候群]、PAX8 / PPARγ再構成、複数のヘテロ接合性喪失などです。RAS遺伝子変異またはTERT遺伝子プロモーター領域の変異は認められず。[Thyroid. 2020 Aug;30(8):1120-1131.]
成人と同じく、小児にも橋本病を基盤とする腺腫様甲状腺腫が存在します。最も、橋本病の罹病期間は、大人と比べて遥かに短いため、腺腫様甲状腺腫にまで発展するケースは少ない。下記は、成長障害から甲状腺機能低下症と、橋本病を基盤とする腺腫様甲状腺腫が見つかった9歳女児のケースです。
甲状腺関連の上記以外の検査・治療 長崎甲状腺クリニック(大阪)
- 甲状腺編
- 甲状腺編 part2
- 内分泌代謝(副甲状腺/副腎/下垂体/妊娠・不妊等
も御覧ください
長崎甲状腺クリニック(大阪)とは
長崎甲状腺クリニック(大阪)は日本甲状腺学会認定 甲状腺専門医[橋本病,バセドウ病,甲状腺超音波(エコー)検査など]による甲状腺専門クリニック。大阪府大阪市東住吉区にあります。平野区,住吉区,阿倍野区,住之江区,松原市,堺市,羽曳野市,八尾市,天王寺区,東大阪市,浪速区,生野区も近く。